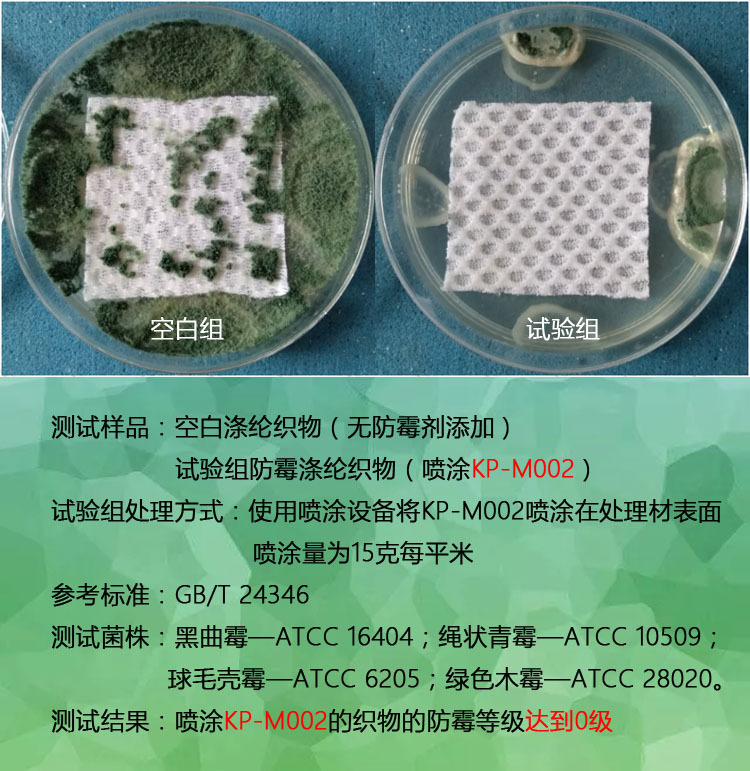
undefined
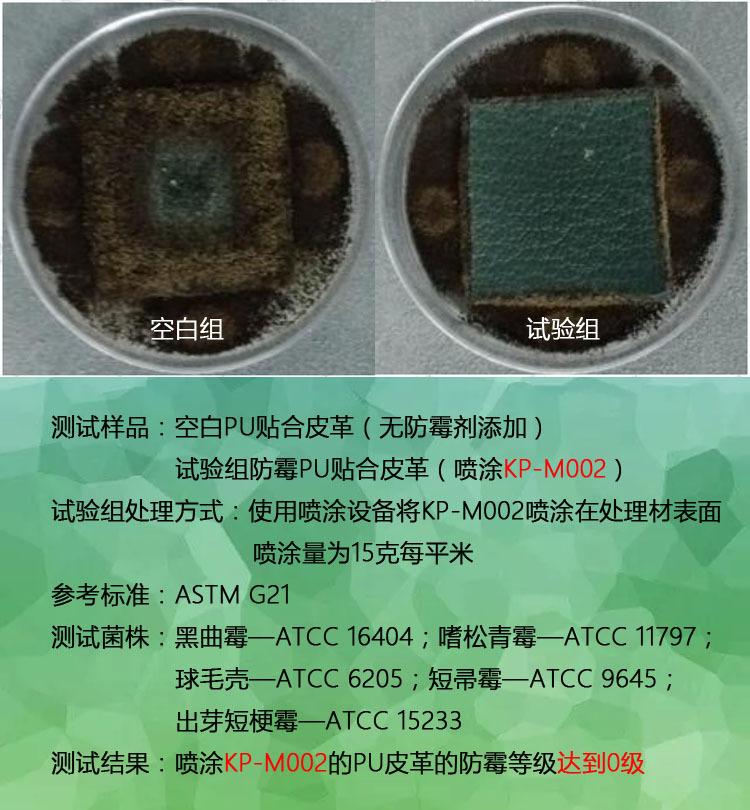
undefined

防霉喷剂 长效防霉剂
- 供应商
- 佛山科普茵生物科技有限公司
- 认证
- 品牌
- 科普茵
- 型号
- KEPUYIN-M002
- 产地
- 广东
- 联系电话
- 0757-88788686
- 手机号
- 18620907734
- 经理
- 陈师
- 所在地
- 佛山市南海区大沥镇盐步横江横沙路88号厂房的2楼(住所申报)
- 更新时间
- 2021-10-22 10:56

防霉喷剂KP-M002概述
1、外观 无色透明液体;2、密度 0.98~1.10g/ml;3、耐热性小于250℃;4、Ph(25℃)5.0~8.0;5、有效含量 大于10%
防霉喷剂KP-M002是采用分析纯的微生物杀灭剂复配而成。具有极高的安全性,无毒、无刺激、无色、气味轻微;操作简单,易于处理,适用于成品的防霉抗菌后处理。对黑曲霉、黄曲霉、绿色木霉、球毛壳霉等数百种致病菌都有优异的杀灭作用。

防霉喷剂KP-M002特点
1、广谱、长效防止病毒、细菌、真菌在其表面的生长,有效防止疾病的传播;
2、根据特殊需求可以使用纯水性配方;
3、操作简单,方便使用,几乎任何产品的表面都可以处理;
4、活性基于分析纯组分,效果更加持久;
5、作用温和,无腐蚀、无漂白;
6、毒性低,不含重金属,符合欧盟相关法规;
7、透明,不改变基材的颜色和其它物理化学性质。
防霉喷剂KP-M002应用范围
皮制品,木制品,纺织品,塑料制品,包装类产品,墙壁,家具等等。

防霉喷剂KP-M002使用注意事项
1、防霉喷剂KP-M002采用喷涂和滚涂的方式处理,防霉原理是在产品表面形成一层防霉抗菌层,遇到霉菌主动将其杀灭,确保产品即使在潮湿的环境下也不会发霉。
2、建议防霉喷剂一般使用量为:15-25克每平方米,根据产品的发霉风险酌情使用,特殊环境需工程师现场指导。
3、备注:防霉喷剂对易过敏者会造成眼睛和皮肤有刺激,使用操作时必须戴手套、眼罩和口罩。